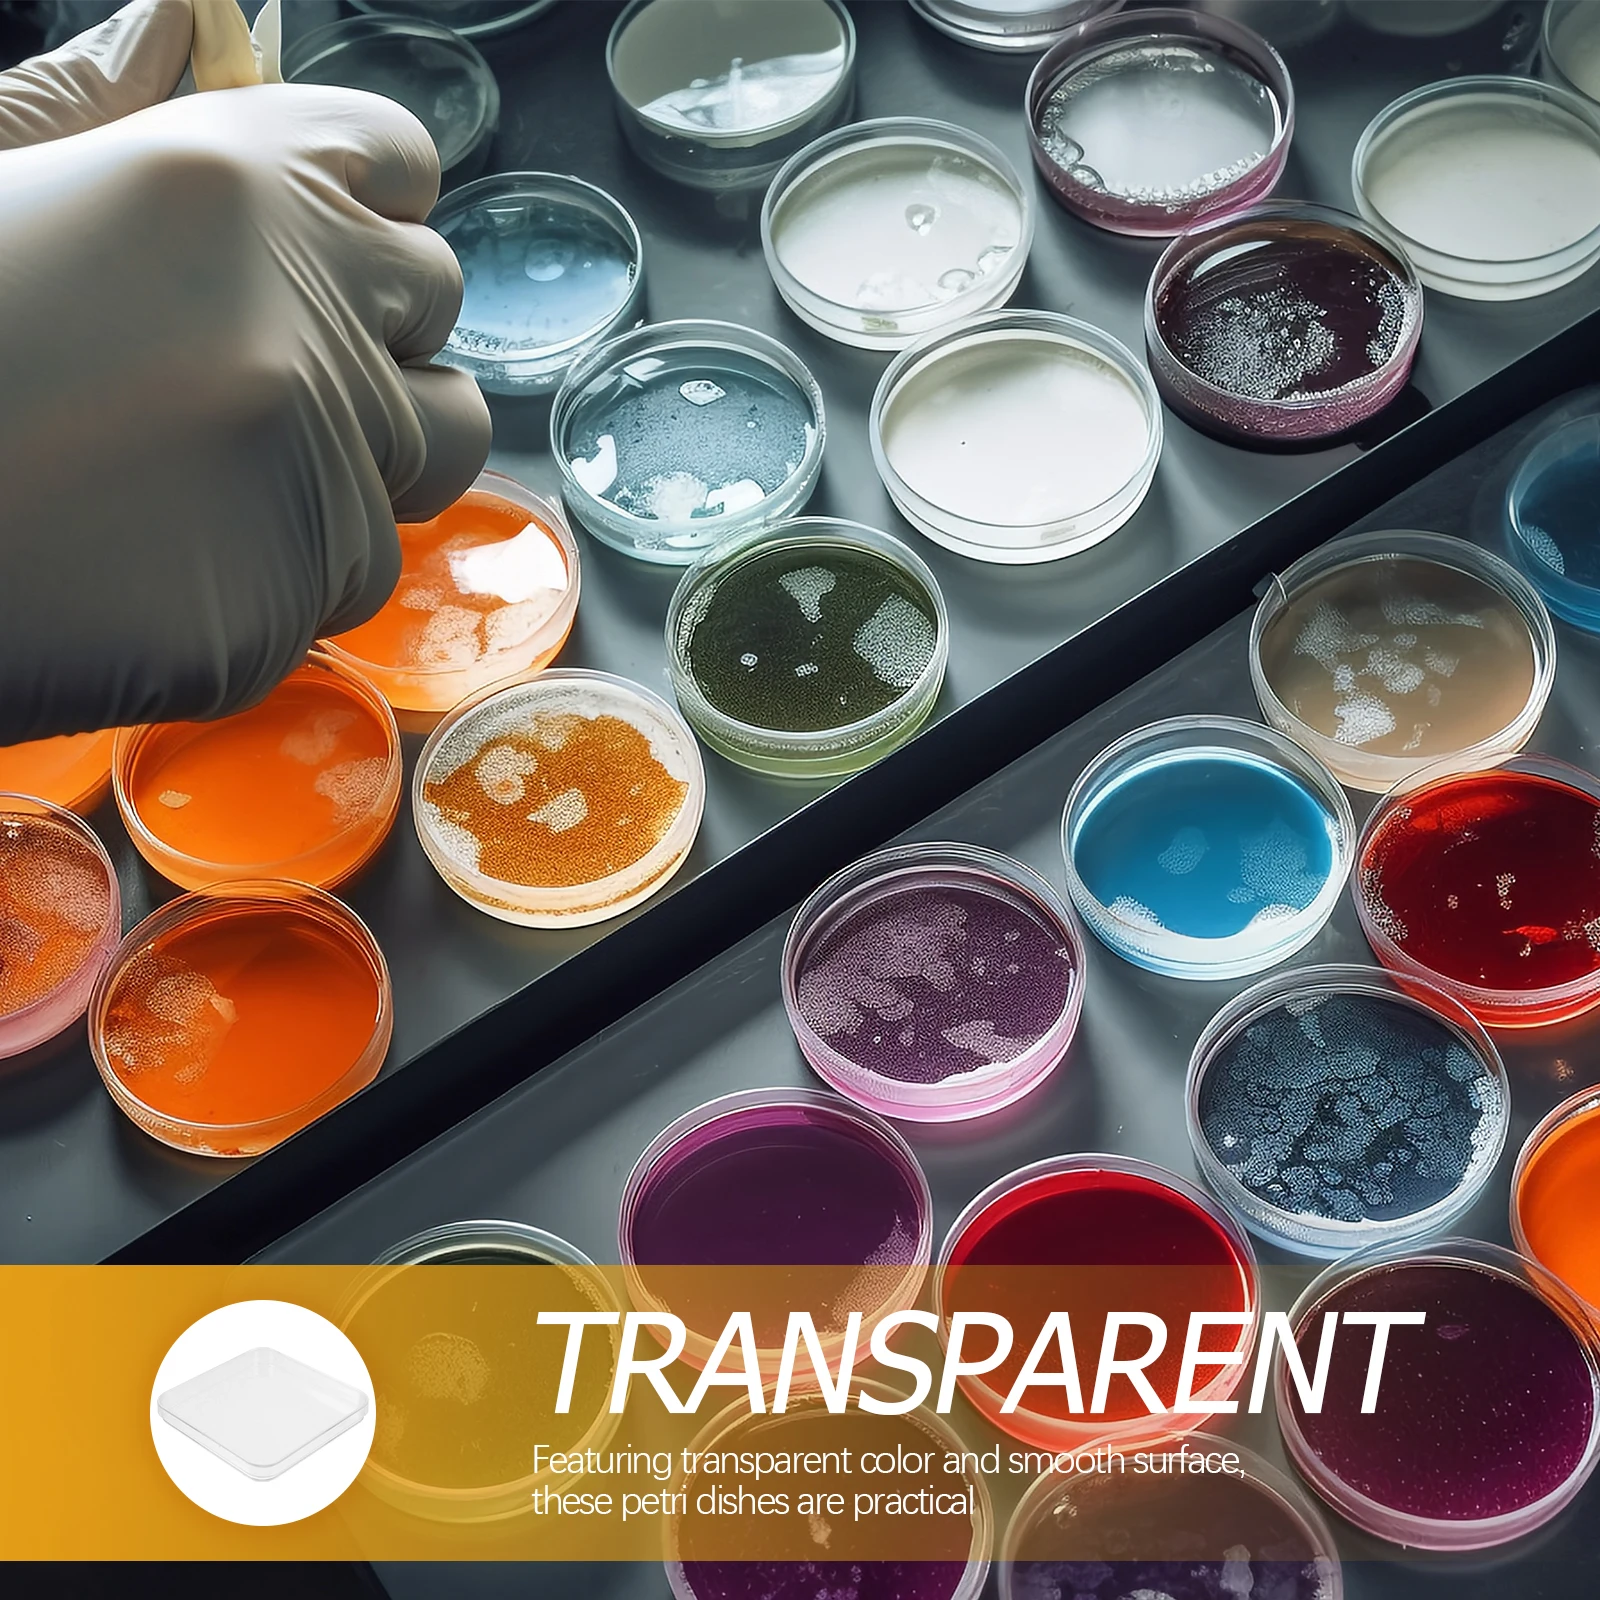
10Pcs Clear Petri Dishes with Lid Small Plastic Culture Plates Laboratory Experimental Equipment for Science Research

Черный цельный женский купальник с длинными рукавами консервативный живот тонкий купальник французский ретро спа купальный костюм













sku: 1005004701961572
ACCORDING TO OUR RECORDS THIS PRODUCT IS NOT AVAILABLE NOW
$25.45
Shipping from: China
Customers also viewed

$28.26
XMAX 300 Accessories Motorcycle Carbon Fiber Trim Parts For Yamaha XMAX300 Xmax 300 2017-2022 Carbon Fiber Stripe Shell Kit
aliexpress.ru
$283.50
4Gifts New ABS Full Fairings Kit Fit For KAWASAKI ZX-6R ZX6R 636 2007 2008 07 08 Bodywork Set Custom Green
aliexpress.ru
$239.00
Девир замши (водяной насос) на 504033770 ежедневно г., г., KARSAN J10, EURO4, 02, евро5
aliexpress.ru
$7.95
Товары для хоккея, тренировочные шайбы для хоккея, тренировочные шайбы для ежедневного обучения, шайбы для хоккея
aliexpress.ru
$22.78
For Bot W10 Accessories Robot Vacuum Cleaner Main Side Brush HEPA Filter Mop Cloth Replacement Clean
aliexpress.com
$21.71
Creative Tissue Box Living Room Home Restaurant Paper Box Remote Control Coffee Table Storage Cute Light Luxury Cat Organizer
aliexpress.com
$97.44
33699 Constant Temperature Wall In Concealed Shower Faucet On-Off Valve Em bedded Box Shower Mixing Water Switch Valve Controlle
aliexpress.com
$7.90
Glass Kitchen Creative Transparent Seasoning Cans Spice Rack Condiment Bottles Pepper Honey Pickles Storage Glass Bottles S077C
aliexpress.com
$30.50
Classics Fashion Closed Toe Sandals Women Solid Buckle Casual Back Strap Sandals Hoof Heels Med Ankle Strap Shoes
aliexpress.com
$6.56
Nate Diaz Mma 2017 Slim Fit T-Shirt Summer Mens Printed T Shirt Cotton Simple Best Tee Shirt Online Brand-Clothing
aliexpress.com
$17.96
Stand Collar Blouse Body Shirt Women Blouses Tops Short / Long Sleeve Bodysuits Formal Prevent Exposure Shirts Plus Size Blusas
aliexpress.com
$0.15
(1Pcs/Sell) Feather DIY Designer Transfer Nails Art Sticker Colorful Fantacy Flowers Nail Stickers Wraps Foil Sticker manicure
aliexpress.com
$2.61
ARWA Alloy Plated Antique Silver Elegant Ballet Dancer Girl Necklace Pendant Chain Mental Jewelry For Women Girls Gift Souvenir
aliexpress.com
$3.99
KISSCASE Tempered Glass Case For iPhone 6 7 Plus Smile Love Heart Couples Cases For iPhone X 7 8 Plus Glass Cover Coques Capinha
aliexpress.com
$14.10
Polychromatic Gymnast Girl Rhinestone Pendant Jewelry Gymnastics Team design for woman
aliexpress.com
$1.12
Yinuoda For iphone 7 6 X Case Czech Republic Switzerland Germany Flag Painted Phone Case for iPhone 8 7 6 6S Plus X 5 5S SE 5C 4
aliexpress.com
$25.00
10/ 20/ 30/ 50/ 100 Pieces / Lot Smochm Milanese Stainless Steel Strap for Apple Watch 42MM 44MM 45MM 49MM and 38MM 40MM 41MM
aliexpress.com
$17.39
Fashion Solid Color Ladies Shoulder Bag Ladies Mini Pu Leather Shoulder Bag Women's Metal Chain Shoulder Bag Purses 2019 New
aliexpress.com
$6.00
Asian Nations Flags 3.8*6.3cm Patch Saudi Arabia Thailand Qatar Turkey Malaysia Oman National Flags Patch Embroidered Decorative
aliexpress.com
$2.41
Flamingo Baby Insulation Thermal Bags Portable Kids Feeding Food Bag Infant Breast Milk Keep Warm Outdoor Waterproof Tote BB5130
aliexpress.com
$4.67
Nordic Style Metal Tray Gold Storage Tray Round Dish Fruit Tea Tray Simple Decoration Home
aliexpress.com
$25.00
Fsqjgq Womens Shoes Women s Gymnastics Running Breathable Sport Ladies Women s Mesh Shoes Splicing Fabric Women s Shows for Women Tennis Shoes Womens Black 41
walmart.com$4.99
12V 10 Way 4pin Fan Hub Speed Controller Regulator For Computer Case With PWM Connection Cable CPU Fan Dedicated Interfa
banggood.com
$839.95
JCZK 300C 470L DFC 6CH 3D Super Simulation Smart RC Helicopter RTF With GPS One-key Return Hover
aliexpress.com
$5.74
HIPERDEAL 18650 charger 4Pcs 3.7V 18650 9800mah Li-ion Rechargeable Battery For LED Flashlight Torch Jun27
aliexpress.com
$2.15
Milk White Long Ballerina Nails Glossry Shiny Pure Color Extra Long Acrylic Nail Tips gel Polish Cover 24
aliexpress.com
$159.76
300MJ Shockwave Therapy Machine Pain Relief Back Relax Portable Ultrasound Physiotherapy Equipment ED Treatment Body Massager
aliexpress.com
$37.45
Motorcycle Parts Ignition Key Switch Lock Fuel Oil Tank Cover For CFMOTO 650MT 400NK 650NK
aliexpress.com
$5.49
L-Lu G-Guang L-Link C-Click Phone Case For Samsung S25,S24,S21,S22,S23,S30,Ultra,S20,Plus,Fe,Lite,10,9,5G Black Cover
aliexpress.ru
$11.06
I'm Not Old I'm Classic Funny Car Vintage Mens & Womens Cars T-Shirt Grandpa Father's Day Novelty Gift Retro Style Saying Tee
aliexpress.ru$0.96
Jardin Coffee Pouch Korean Pouch Drink Signature Coffee Americano Jardin Iced Peach Tea
shopee.co.id
$14.67
10Pcs Clear Petri Dishes with Lid Small Plastic Culture Plates Laboratory Experimental Equipment for Science Research
aliexpress.ru
$7.79
For Suzuki V-Strom 800DE DL800 DL 800 DE 2022 2023 2024 Motorcycle Windscreen Adjusters CNC Windshield Bracket Accessories
aliexpress.ru
$1.47
4 шт. алюминиевые автомобильные шины, шток клапана, воздушные колпачки, противоугонные герметичные крышки для Volkswagen VW R-line GTI UPi Golf Passat Jetta Touran
aliexpress.ru








